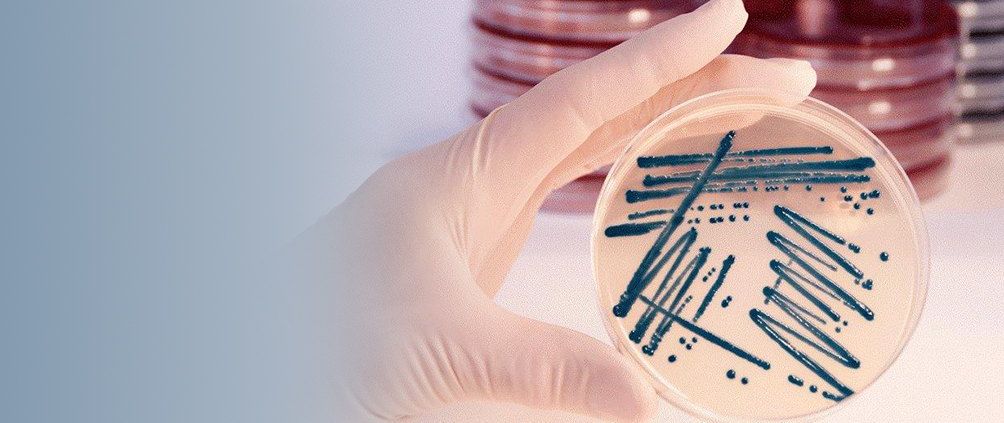
Bilde av dyrkningsskål

Analyseliste og rekvisisjoner for helsesektoren
På ous.labfag.no finner du samlet informasjon for rekvirenter i primær-, kommune- og spesialisthelsetjenesten om OUS sine laboratorieanalyser, hvordan rekvirere analyser elektronisk eller via rekvisisjoner. Du finner også informasjon om forsendelse av prøver, hvordan bestille prøvetakingsutstyr og hvordan komme i kontakt med laboratoriene og kunderådgiverne.